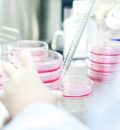

بازداشت عامل قتل در چیتگر
اعمال محدودیتهای ترافیکی راهپیمایی ۱۳ آبان در رشت
آماده باش امدادگران هلال احمر در پی هشدار نارنجی هواشناسی
گلستانی ها ۳۰۰۰ تخته پتو به مردم لبنان هدیه کردند